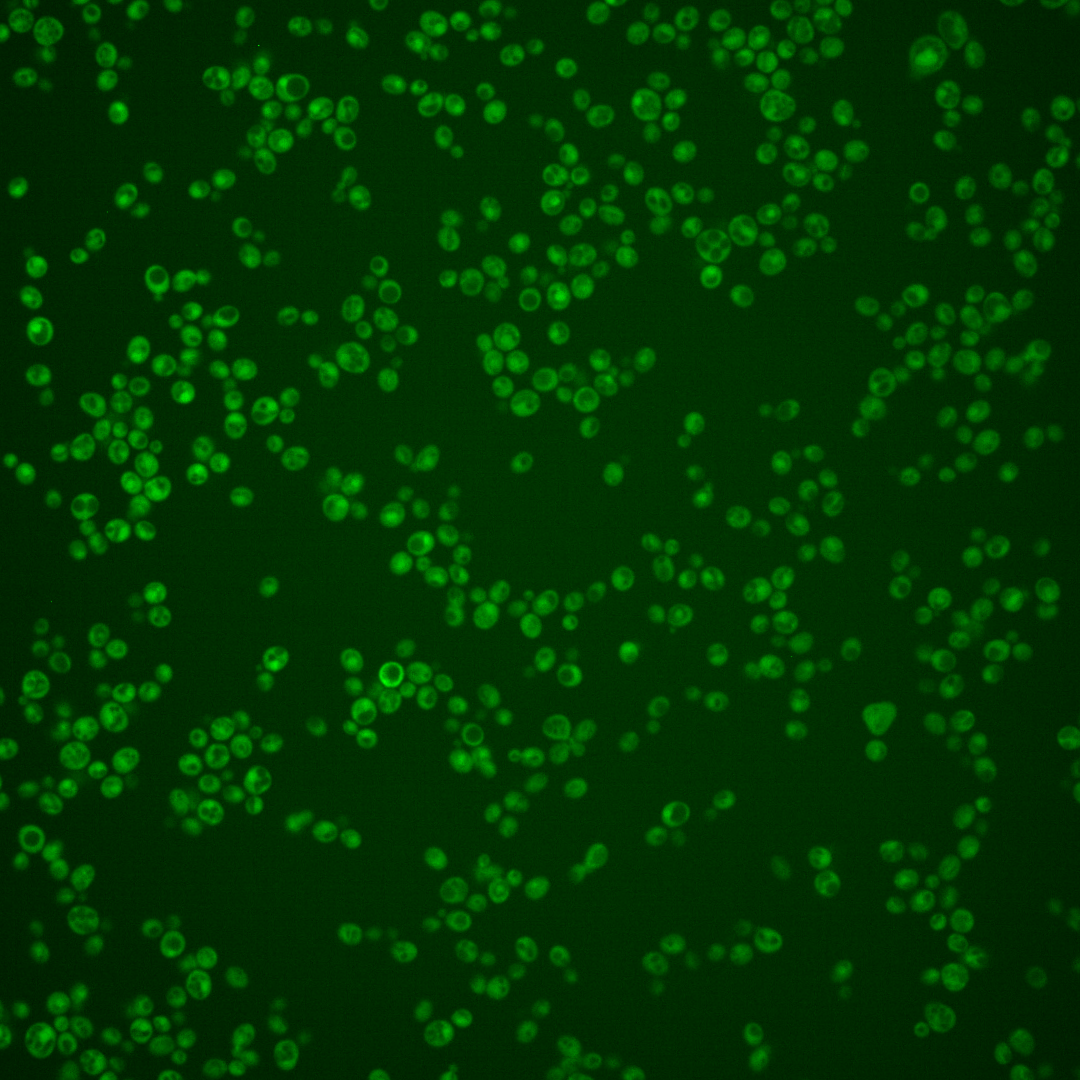
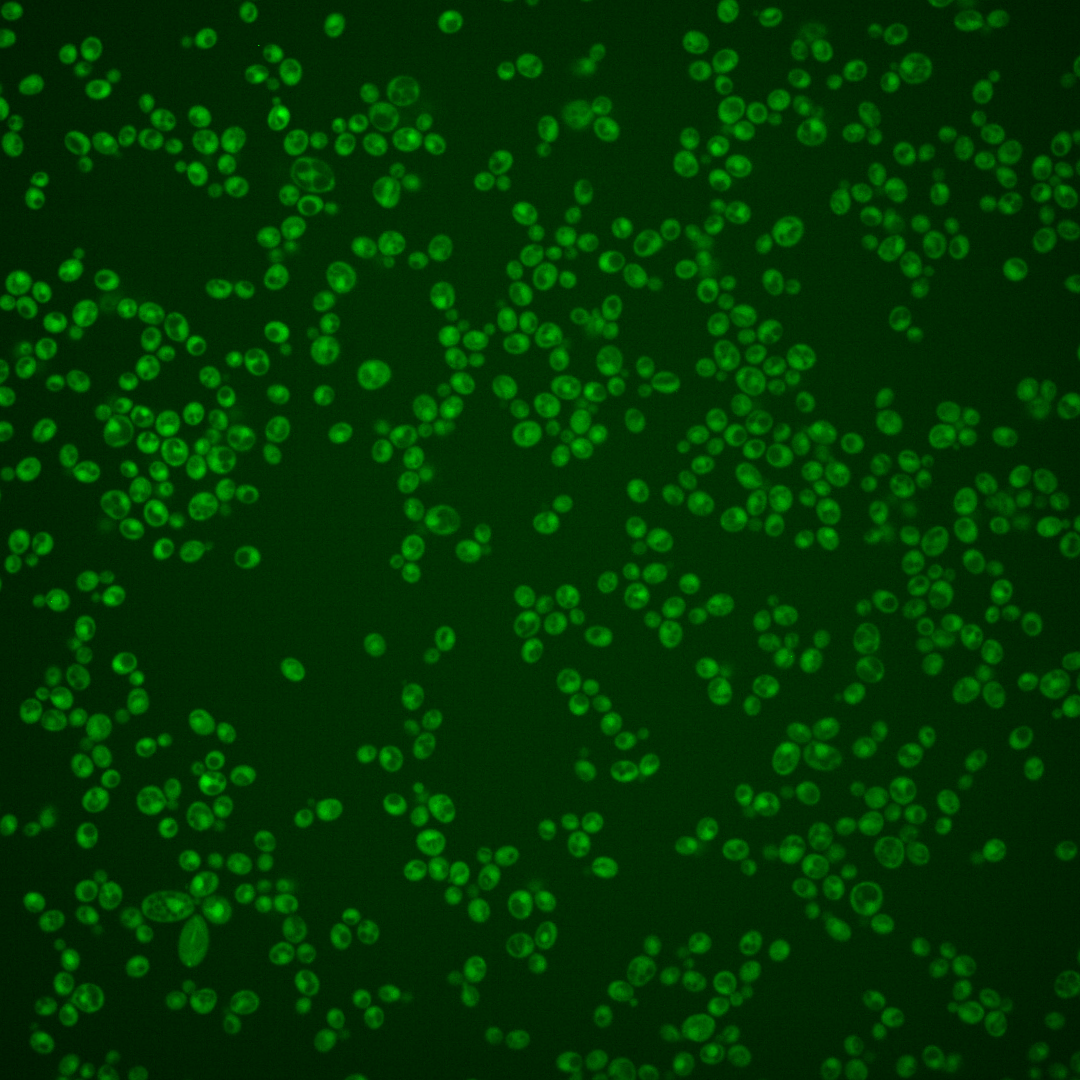
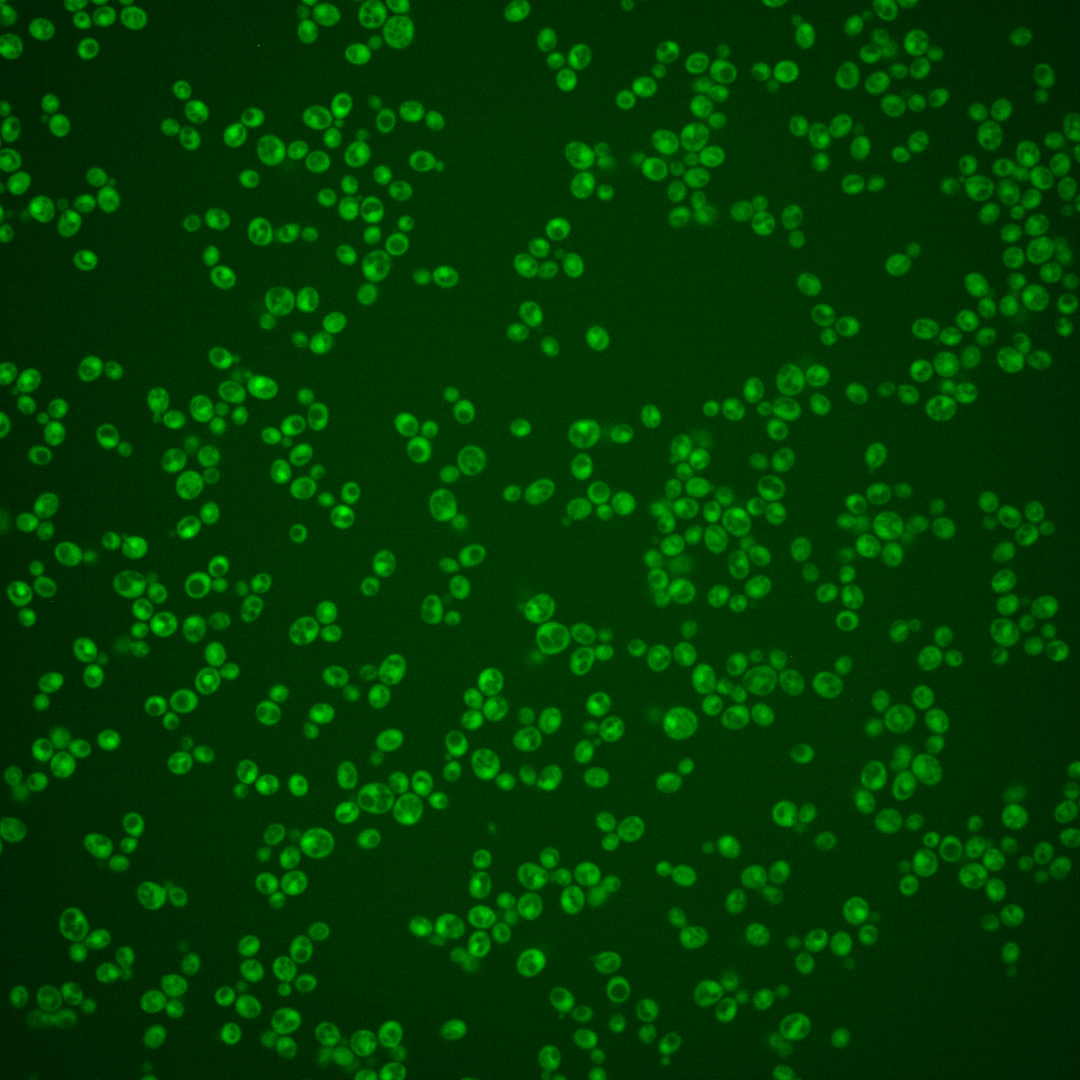
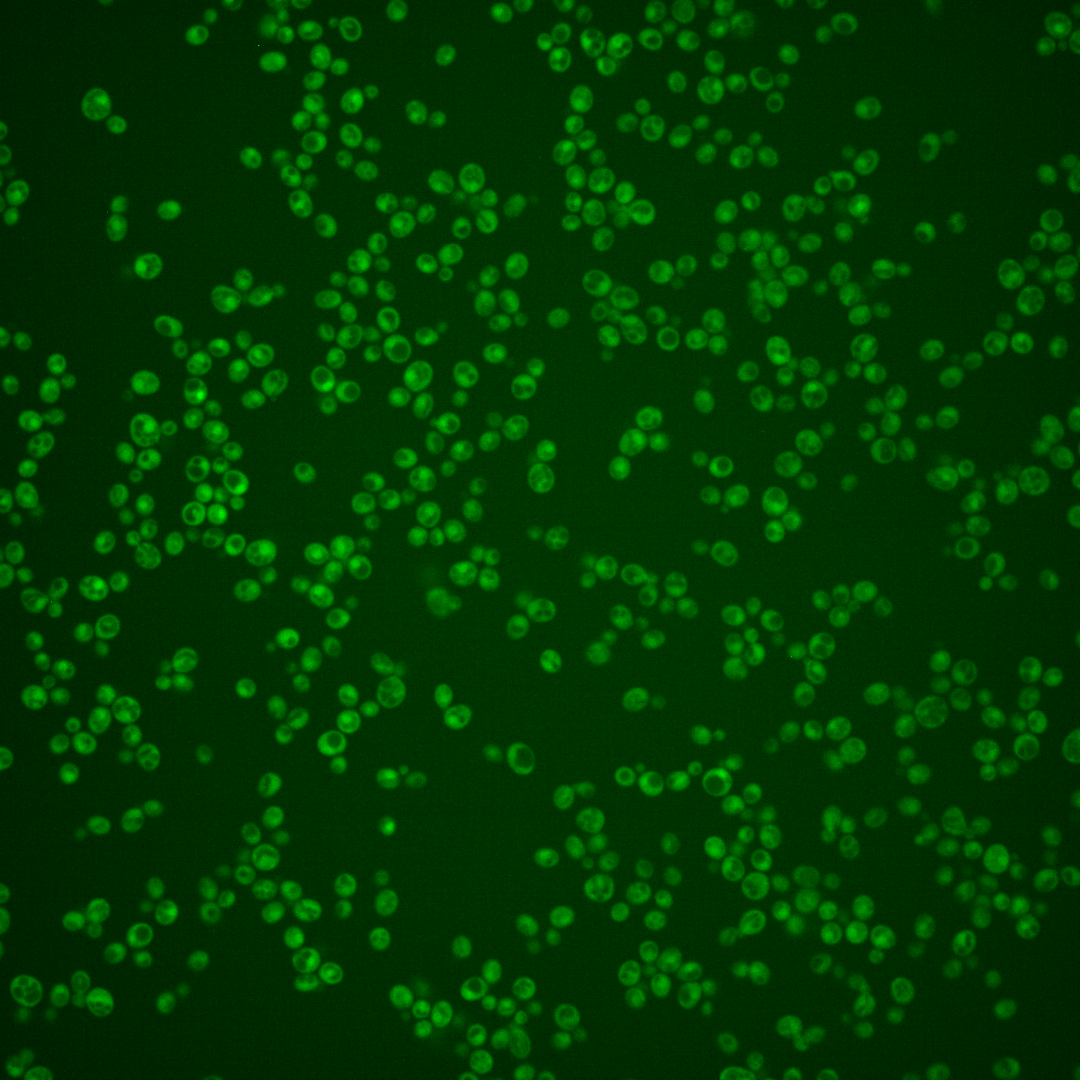

| Standard name | |
|---|---|
| Human Ortholog | |
| Description | Protein containing a Kruppel-type zinc-finger domain; similar to Stp1p, Stp2p; predicted transcription factor; relative distribution to the nucleus increases upon DNA replication stress; STP4 has a paralog, STP3, that arose from the whole genome duplication |
Micrographs




















































































Sub-cellular Localization
Yeast GFP Assignment
Protein Abundance
Localization Change
External localization resources
| ensLOC | DeepLoc | |||||||||||||||||||||||
|---|---|---|---|---|---|---|---|---|---|---|---|---|---|---|---|---|---|---|---|---|---|---|---|---|
| Localization | WT1 | WT2 | WT3 | RAP60 | RAP140 | RAP220 | RAP300 | RAP380 | RAP460 | RAP540 | RAP620 | RAP700 | HU80 | HU120 | HU160 | rpd3Δ_1 | rpd3Δ_2 | rpd3Δ_3 | WT1 | WT2 | WT3 | AF100 | AF140 | AF180 |
| Cortical Patches | 0 | 0 | 0 | 0 | 0 | 0 | 0 | 0 | 0 | 0 | 0 | 0 | 0 | 0 | 0 | – | 0 | 1 | 4 | 0 | 1 | 0 | 1 | 4 |
| Bud | 0 | 1 | 0 | 0 | 1 | 0 | 2 | 0 | 3 | 1 | 3 | 4 | 0 | 1 | 0 | – | 0 | 1 | 0 | 0 | 0 | 1 | 3 | 7 |
| Bud Neck | 0 | 0 | 0 | 0 | 4 | 2 | 1 | 3 | 0 | 4 | 0 | 2 | 0 | 0 | 0 | – | 2 | 0 | 1 | 0 | 0 | 0 | 1 | 3 |
| Bud Site | 0 | 0 | 0 | 0 | 0 | 0 | 0 | 0 | 1 | 0 | 0 | 0 | 0 | 0 | 0 | – | 0 | 0 | – | – | – | – | – | – |
| Cell Periphery | 0 | 0 | 0 | 0 | 1 | 1 | 0 | 1 | 2 | 0 | 0 | 0 | 0 | 1 | 0 | – | 3 | 4 | 0 | 1 | 0 | 0 | 1 | 1 |
| Cytoplasm | 209 | 82 | 77 | 34 | 107 | 93 | 153 | 120 | 98 | 96 | 82 | 84 | 201 | 286 | 244 | – | 263 | 206 | 160 | 87 | 50 | 104 | 202 | 211 |
| Endoplasmic Reticulum | 0 | 1 | 0 | 0 | 0 | 1 | 0 | 0 | 0 | 0 | 1 | 0 | 1 | 1 | 0 | – | 26 | 20 | 1 | 0 | 1 | 0 | 1 | 3 |
| Endosome | 0 | 0 | 0 | 0 | 0 | 0 | 0 | 0 | 0 | 0 | 0 | 0 | 0 | 0 | 0 | – | 2 | 5 | 5 | 3 | 1 | 1 | 0 | 0 |
| Golgi | 0 | 0 | 0 | 0 | 0 | 0 | 0 | 0 | 0 | 0 | 0 | 0 | 1 | 0 | 0 | – | 0 | 0 | 1 | 0 | 0 | 1 | 0 | 0 |
| Mitochondria | 30 | 8 | 13 | 5 | 11 | 17 | 66 | 29 | 38 | 57 | 66 | 54 | 3 | 2 | 1 | – | 8 | 6 | 38 | 10 | 18 | 5 | 9 | 14 |
| Nucleus | 0 | 0 | 1 | 0 | 0 | 1 | 2 | 2 | 0 | 0 | 0 | 0 | 0 | 0 | 0 | – | 0 | 1 | 0 | 0 | 0 | 0 | 0 | 0 |
| Nuclear Periphery | 0 | 0 | 0 | 0 | 0 | 0 | 0 | 0 | 1 | 1 | 2 | 0 | 0 | 0 | 0 | – | 0 | 0 | 0 | 0 | 0 | 0 | 0 | 0 |
| Nucleolus | 0 | 0 | 0 | 0 | 0 | 0 | 2 | 0 | 1 | 0 | 0 | 0 | 0 | 0 | 0 | – | 0 | 0 | 0 | 0 | 0 | 0 | 0 | 0 |
| Peroxisomes | 0 | 0 | 0 | 0 | 0 | 0 | 0 | 0 | 0 | 0 | 0 | 0 | 0 | 0 | 0 | – | 3 | 0 | 1 | 0 | 0 | 0 | 0 | 0 |
| SpindlePole | 0 | 1 | 0 | 0 | 0 | 0 | 1 | 0 | 0 | 2 | 0 | 1 | 0 | 0 | 0 | – | 1 | 1 | 4 | 3 | 1 | 2 | 3 | 5 |
| Vac/Vac Membrane | 0 | 1 | 1 | 0 | 0 | 0 | 0 | 0 | 1 | 2 | 0 | 1 | 3 | 1 | 0 | – | 16 | 9 | 9 | 4 | 1 | 1 | 2 | 6 |
| Unique Cell Count | 222 | 91 | 85 | 35 | 113 | 99 | 181 | 136 | 121 | 126 | 119 | 118 | 206 | 289 | 244 | 282 | 223 | 234 | 116 | 80 | 124 | 233 | 267 | |
| Labelled Cell Count | 239 | 94 | 92 | 39 | 124 | 115 | 227 | 155 | 145 | 163 | 154 | 146 | 209 | 292 | 245 | 324 | 254 | 234 | 116 | 80 | 124 | 233 | 267 | |
Yeast GFP Assignment
Protein Abundance
| Screen | WT1 | WT2 | WT3 | RAP60 | RAP140 | RAP220 | RAP300 | RAP380 | RAP460 | RAP540 | RAP620 | RAP700 | HU80 | HU120 | HU160 | rpd3Δ_1 | rpd3Δ_2 | rpd3Δ_3 | AF100 | AF140 | AF180 |
|---|---|---|---|---|---|---|---|---|---|---|---|---|---|---|---|---|---|---|---|---|---|
| Mean Cell GFP Intensity (1e-4) | 3.1 | 3.5 | 3.2 | 3.6 | 3.0 | 3.0 | 2.2 | 3.1 | 2.7 | 2.3 | 2.6 | 2.4 | 3.7 | 4.0 | 3.9 | 4.2 | 5.3 | 5.4 | 3.6 | 3.7 | 4.4 |
| Std Deviation (1e-4) | 0.4 | 0.9 | 1.2 | 1.8 | 1.3 | 1.9 | 1.0 | 1.8 | 1.6 | 1.0 | 1.4 | 1.3 | 1.3 | 1.4 | 1.2 | 1.5 | 2.4 | 2.3 | 1.3 | 1.7 | 1.5 |
| Intensity Change (Log2) | – | – | – | 0.17 | -0.06 | -0.09 | -0.51 | -0.04 | -0.22 | -0.47 | -0.27 | -0.43 | 0.21 | 0.34 | 0.3 | 0.42 | 0.75 | 0.77 | 0.17 | 0.23 | 0.49 |
Localization Change
| Localization | RAP60 | RAP140 | RAP220 | RAP300 | RAP380 | RAP460 | RAP540 | RAP620 | RAP700 | HU80 | HU120 | HU160 | rpd3Δ_1 | rpd3Δ_2 | rpd3Δ_3 |
|---|---|---|---|---|---|---|---|---|---|---|---|---|---|---|---|
| Actin | – | – | – | – | – | – | – | – | – | – | – | – | – | – | – |
| Bud | – | – | – | – | – | – | – | – | – | – | – | – | – | – | – |
| Bud Neck | – | – | – | – | – | – | – | – | – | – | – | – | – | – | – |
| Bud Site | – | – | – | – | – | – | – | – | – | – | – | – | – | – | – |
| Cell Periphery | – | – | – | – | – | – | – | – | – | – | – | – | – | – | – |
| Cyto | – | – | – | – | – | – | – | – | – | – | – | – | – | – | – |
| Endoplasmic Reticulum | – | – | – | – | – | – | – | – | – | – | – | – | – | – | – |
| Endosome | – | – | – | – | – | – | – | – | – | – | – | – | – | – | – |
| Golgi | – | – | – | – | – | – | – | – | – | – | – | – | – | – | – |
| Mitochondria | – | – | – | – | – | – | – | – | – | – | – | – | – | – | – |
| Nuclear Periphery | – | – | – | – | – | – | – | – | – | – | – | – | – | – | – |
| Nuc | – | – | – | – | – | – | – | – | – | – | – | – | – | – | – |
| Nucleolus | – | – | – | – | – | – | – | – | – | – | – | – | – | – | – |
| Peroxisomes | – | – | – | – | – | – | – | – | – | – | – | – | – | – | – |
| SpindlePole | – | – | – | – | – | – | – | – | – | – | – | – | – | – | – |
| Vac | – | – | – | – | – | – | – | – | – | – | – | – | – | – | – |
| Cortical Patches | – | – | – | – | – | – | – | – | – | – | – | – | – | – | – |
| Cytoplasm | – | – | – | – | – | – | – | – | – | – | – | – | – | – | – |
| Nucleus | – | – | – | – | – | – | – | – | – | – | – | – | – | – | – |
| Vacuole | – | – | – | – | – | – | – | – | – | – | – | – | – | – | – |
External localization resources
Images






























Protein Concentration and Protein Localization Data
| R1 | R2 | R3 | ||||||||||||||||
|---|---|---|---|---|---|---|---|---|---|---|---|---|---|---|---|---|---|---|
| G1 Pre-START | G1 Post-START | S/G2 | Metaphase | Anaphase | Telophase | G1 Pre-START | G1 Post-START | S/G2 | Metaphase | Anaphase | Telophase | G1 Pre-START | G1 Post-START | S/G2 | Metaphase | Anaphase | Telophase | |
| Concentration | 0.266 | 0.2067 | 0.3305 | -0.1805 | 0.2541 | 0.2476 | 1.2908 | 1.2292 | 1.2539 | 1.0097 | 1.6597 | 1.063 | 2.056 | 1.0356 | 1.213 | 2.4598 | 1.3995 | 1.3655 |
| Actin | 0.0517 | 0.0003 | 0.0171 | 0 | 0.0171 | 0.0041 | 0.031 | 0.0003 | 0.0131 | 0.0048 | 0.0222 | 0.001 | 0.0442 | 0.0073 | 0.0117 | 0.0247 | 0.019 | 0.0074 |
| Bud | 0.0038 | 0.0088 | 0.0054 | 0.0001 | 0.0058 | 0.0002 | 0.001 | 0.005 | 0.0006 | 0.0006 | 0.0021 | 0.003 | 0.0007 | 0.0001 | 0.0003 | 0.0005 | 0.0014 | 0.0022 |
| Bud Neck | 0.0024 | 0.0008 | 0.0011 | 0.0003 | 0.0005 | 0.0025 | 0.0089 | 0.0015 | 0.0011 | 0.0005 | 0.0006 | 0.0009 | 0.0026 | 0.0001 | 0.0008 | 0.0002 | 0.0001 | 0.001 |
| Bud Periphery | 0.0049 | 0.0053 | 0.0109 | 0.0001 | 0.009 | 0.0009 | 0.0045 | 0.0025 | 0.0014 | 0.0006 | 0.0047 | 0.0007 | 0.0032 | 0.0001 | 0.0003 | 0.0016 | 0.0049 | 0.0124 |
| Bud Site | 0.0071 | 0.0224 | 0.0058 | 0.0001 | 0.001 | 0.0002 | 0.0083 | 0.0253 | 0.0129 | 0.0008 | 0.0068 | 0.0001 | 0.007 | 0.0022 | 0.0058 | 0.0009 | 0.0002 | 0.004 |
| Cell Periphery | 0.0006 | 0.0004 | 0.0003 | 0 | 0.0002 | 0.0001 | 0.001 | 0.0011 | 0.0014 | 0.0001 | 0.0006 | 0.0001 | 0.0043 | 0.0001 | 0.0002 | 0.0001 | 0.0002 | 0.0002 |
| Cytoplasm | 0.0763 | 0.0707 | 0.0648 | 0.0478 | 0.0472 | 0.131 | 0.0184 | 0.0243 | 0.0441 | 0.026 | 0.0122 | 0.0676 | 0.0499 | 0.0421 | 0.0557 | 0.0153 | 0.022 | 0.0688 |
| Cytoplasmic Foci | 0.0179 | 0.0043 | 0.0145 | 0.0012 | 0.0066 | 0.0102 | 0.028 | 0.0181 | 0.0142 | 0.0171 | 0.0313 | 0.0081 | 0.0263 | 0.0137 | 0.0082 | 0.0086 | 0.0027 | 0.004 |
| Eisosomes | 0.0007 | 0.0001 | 0.0005 | 0 | 0.0003 | 0.0002 | 0.0022 | 0.0001 | 0.0005 | 0.0001 | 0.0003 | 0.0001 | 0.0012 | 0.0003 | 0.002 | 0.0006 | 0.0002 | 0.0001 |
| Endoplasmic Reticulum | 0.0032 | 0.0014 | 0.0024 | 0.0004 | 0.0015 | 0.0017 | 0.0036 | 0.0004 | 0.0013 | 0.0011 | 0.0016 | 0.0007 | 0.0083 | 0.0006 | 0.0018 | 0.0013 | 0.0018 | 0.0009 |
| Endosome | 0.0122 | 0.0007 | 0.006 | 0.0003 | 0.0054 | 0.0031 | 0.0103 | 0.0009 | 0.0118 | 0.0303 | 0.0411 | 0.0015 | 0.0203 | 0.003 | 0.0023 | 0.0113 | 0.003 | 0.003 |
| Golgi | 0.0062 | 0.0001 | 0.003 | 0 | 0.0096 | 0.0005 | 0.0039 | 0.0002 | 0.0068 | 0.0189 | 0.0128 | 0.0002 | 0.0058 | 0.0031 | 0.001 | 0.0066 | 0.0121 | 0.0024 |
| Lipid Particles | 0.0093 | 0.0003 | 0.0046 | 0.0001 | 0.0101 | 0.0011 | 0.013 | 0.0012 | 0.0059 | 0.0111 | 0.0132 | 0.0005 | 0.0154 | 0.0049 | 0.0035 | 0.0035 | 0.0003 | 0.0052 |
| Mitochondria | 0.0062 | 0.0004 | 0.0169 | 0.0003 | 0.0309 | 0.0022 | 0.0109 | 0.0005 | 0.0072 | 0.0081 | 0.0224 | 0.0003 | 0.0032 | 0.0022 | 0.0007 | 0.0097 | 0.0015 | 0.0015 |
| None | 0.7061 | 0.8414 | 0.776 | 0.891 | 0.7857 | 0.7814 | 0.8126 | 0.8771 | 0.8558 | 0.8492 | 0.8011 | 0.8896 | 0.7534 | 0.9038 | 0.8861 | 0.8749 | 0.9259 | 0.8542 |
| Nuclear Periphery | 0.0073 | 0.0013 | 0.0098 | 0.0005 | 0.0018 | 0.0027 | 0.0096 | 0.0003 | 0.0019 | 0.0014 | 0.0012 | 0.0011 | 0.012 | 0.0007 | 0.002 | 0.0104 | 0.0019 | 0.0045 |
| Nucleolus | 0.0017 | 0.0013 | 0.0014 | 0.0007 | 0.0008 | 0.0013 | 0.0015 | 0.0078 | 0.0005 | 0.0005 | 0.0008 | 0.0006 | 0.0011 | 0.0003 | 0.0008 | 0.0007 | 0.0001 | 0.0005 |
| Nucleus | 0.0573 | 0.0344 | 0.0408 | 0.0561 | 0.0534 | 0.0443 | 0.0034 | 0.0217 | 0.0069 | 0.013 | 0.002 | 0.0122 | 0.0137 | 0.0083 | 0.0082 | 0.0021 | 0.0007 | 0.0152 |
| Peroxisomes | 0.0104 | 0.0002 | 0.005 | 0 | 0.0085 | 0.0005 | 0.0139 | 0.0013 | 0.0076 | 0.0102 | 0.0101 | 0.0055 | 0.0111 | 0.0024 | 0.0048 | 0.0033 | 0.0002 | 0.0015 |
| Punctate Nuclear | 0.012 | 0.0044 | 0.011 | 0.0007 | 0.0022 | 0.0097 | 0.0115 | 0.0038 | 0.0031 | 0.0036 | 0.0042 | 0.0058 | 0.0125 | 0.0043 | 0.003 | 0.0214 | 0.0009 | 0.0099 |
| Vacuole | 0.002 | 0.001 | 0.0017 | 0.0004 | 0.0014 | 0.0015 | 0.0017 | 0.0063 | 0.0012 | 0.0016 | 0.0064 | 0.0005 | 0.0024 | 0.0003 | 0.0005 | 0.0009 | 0.0005 | 0.0005 |
| Vacuole Periphery | 0.0008 | 0.0001 | 0.0011 | 0.0001 | 0.0009 | 0.0004 | 0.0008 | 0.0003 | 0.0005 | 0.0005 | 0.0025 | 0.0001 | 0.0015 | 0.0001 | 0.0001 | 0.0013 | 0.0003 | 0.0004 |
Sequencing Data
| R1 | R2 | |||||||||
|---|---|---|---|---|---|---|---|---|---|---|
| G1 Post-START | S/G2 | Metaphase | Anaphase | Telophase | G1 Post-START | S/G2 | Metaphase | Anaphase | Telophase | |
| Gene Expression | 2.9963 | 0.6696 | 1.4907 | 3.1294 | 0.9712 | 2.9947 | 1.1849 | 3.8843 | 2.2661 | 1.9116 |
| Translational Efficiency | – | – | – | – | – | – | – | – | – | – |
Hit Data
| Dataset | Hit |
|---|---|
| Protein Concentration | ✘ |
| Protein Localization | ✘ |
| Gene Expression | ✘ |
| Translational Efficiency | – |
Endocytosis
| Temp | Actin Patch (Sac6-tdTomato) | Cortical Patch (Sla1-GFP) | Late Endosome (Snf7-GFP) | Vacuole (Vph1-GFP) |
|---|---|---|---|---|
| 37℃ | ||||
| RT |
Cell Cycle Omics
CYCLoPs (Stp4-GFP)
| Gene / Allele | Actin Patch (Sac6-tdTomato) | Cortical Patch (Sla1-GFP) | Late Endosome (Snf7-GFP) | Vacuole (Sac6-tdTomato) |
|---|
| Gene | Images |
|---|
| Gene | Images |
|---|
Images are not yet available
Images are not yet available